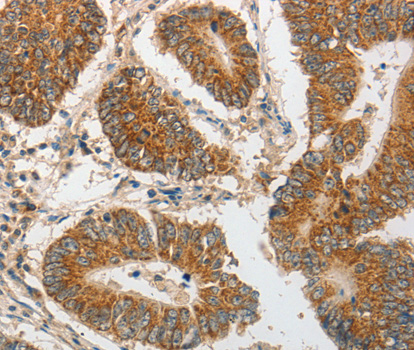
A3072: image 2

For quotations, please use our online quotation form, and you may also contact us by
service@kendallscientific.com
+1-888.733.6849 (Toll-free)
+1-617.299.7367 (Int’l))
+1-888.733.6849
Our customer service representatives are available 24 hours, Monday through Friday to assist you.| Reactivity | Human Mouse Rat |
| Tested applications | WB IHC |
| Recommended Dilution | WB 1:500 - 1:1000 IHC 1:50 - 1:100 |
| Calculated MW | 90kDa |
| Observed MW | Refer to Figures |
| Immunogen | A synthetic peptide of human PIBF1 |
| Storage Buffer | Store at -20℃. Avoid freeze / thaw cycles. Buffer: PBS with 0.02% sodium azide, 50% glycerol, pH7.3. |
| Concentration | d |
| Synonym | PIBF; CEP90; C13orf24; RP11-505F3.1 |

Western blot analysis of extracts of mouse heart cells, using PIBF1 antibody.
Immunohistochemistry of paraffin-embedded human colon tissue using PIBF1 antibody.

Immunohistochemistry of paraffin-embedded rat kidney tissue using PIBF1 antibody at dilution of 1:200 (x40 lens).

Immunohistochemistry of paraffin-embedded human rectal cancer tissue using PIBF1 antibody at dilution of 1:200 (x40 lens).

Immunohistochemistry of paraffin-embedded Rat testis using PIBF1 antibody at dilution of 1:100 (x40 lens).
Progesterone-induced-blocking factor 1 is a protein that in humans is encoded by the PIBF1 gene. It has been shown to localize to the centrosome and has also been named CEP90. Mediator of progesterone that by acting on the phospholipase A2 enzyme interferes with arachidonic acid metabolism, induces a Th2 biased immune response, and by controlling NK activity exerts an anti-abortive effect.
N/A